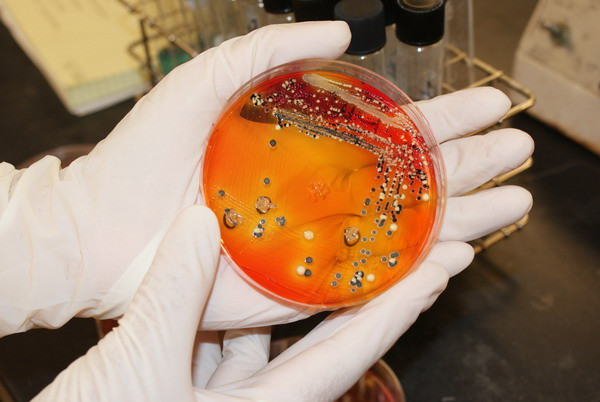
Hàng trăm người nhiễm vi khuẩn salmonella tại Australia ảnh 1

Vi khuẩn salmonella là nguyên nhân gây ngộ độc thức ăn hàng đầu tại Mỹ. (Nguồn: missouri.edu)
Vi khuẩn salmonella là nguyên nhân gây ngộ độc thức ăn hàng đầu tại Mỹ. (Nguồn: missouri.edu)
Một lô trứng hỏng bị coi là nguyên nhân của đợt nhiễm khuẩn salmonella trong dịp Melbourne Cup vừa qua tại Brisbane.
Đợt nhiễm khuẩn đã cướp đi sinh mạng của một người và khiến hơn 220 người gặp vấn đề sức khỏe.
Giới chức y tế nước này cho biết 700 người có thể đã nhiễm khuẩn salmonella trong đợt này.
Giới chức Australia đang lo ngại về chiều hướng xấu của đợt nhiễm khuẩn khi có thêm bảy người phải nhập viện.
Công ty Piccalilli Catering bị coi là nguồn phát bệnh khi dùng trứng hỏng để làm sốt mayonnaise cung cấp cho 40 địa điểm tại Brisbane nhân dịp Melbounrne Cup hồi tuần trước.
Theo giới chuyên môn, con số người nhiễm khuẩn đang ngày một tăng và những ngày tới vẫn đáng báo động do nhiều người có thể bị ốm tới hai tuần sau khi phát bệnh.
Vi khuẩn salmonella có thể lây sang người qua thực phẩm ôi thiu như thịt, trứng.
Triệu chứng của bệnh bao gồm sốt, đau đầu, tiêu chảy, đau bụng và nôn mửa. Bệnh kéo dài từ 4-7 ngày, có thể gây nguy hiểm cho người già và trẻ em./.
































